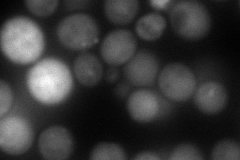
YPL267W
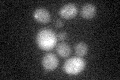
YPL267W
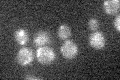
YPL267W

View description
Pseudosubstrate inhibitor of the anaphase-promoting complex/cyclosome (APC/C), that suppresses APC/C [Cdh1]-mediated proteolysis of mitotic cyclins; associates with Cdh1p, Bmh1p and Bmh2p; cell cycle regulated protein
Localization:
Intensity:
Fold change:
Significance:
-
C’ GFP library in SD

below threshold18.47 -
N' NOP1pr-GFP in SD

cytosol,nucleus31.0258 -
N' TEF2pr-mCherry in SD
punctate119.999 -
N' NATIVEpr-GFP in SD

below threshold28.6227 -
N' TEF2pr-VC and Cyto-VN in SD

#N/A0 -
C’ GFP library in SD+DTT
cytosol191.02No -
C’ GFP library in SD+H2O2
cytosol15.350.83No -
C’ GFP library in Starvation Media

cytosol15.970.86No -
C’ GFP library on the background of Pup2-DaMP

below threshold -
C’ GFP library on the background of CCT mutant

below threshold18.62061.00785No
